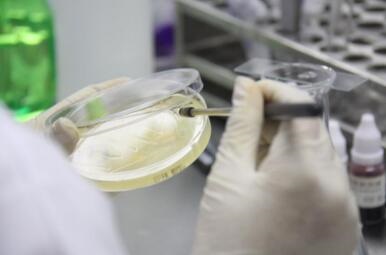
實驗室建設并不難，選對方法很簡單

感谢您访问我们的网站,您可能还对以下资源感兴趣:潜江木橇租售有限公司
亚洲另类无码一区二区三区,日产欧美国产日韩精品,亚洲六月丁香六月婷婷蜜芽,欧美 日韩 国产 成人 在线观看,久久人妻少妇精品系列,国产人妻精品,尤物av在线,国产精品高清中文字幕
网站地图
国产免费高清无需播放器
天天综合视频
国产精品二区中文字幕
另类图片色五月
亚洲成在人的天堂网址
新加坡一级特黄大片
亚洲激情五月天
草逼网站
上海集散中心旅游官网订票
免费观看av在线播放
日韩欧美中文字幕在线播放
国产在线拍揄自揄视频不卡99
中国国语毛片免费观看视频
亚洲精品国产高清一线久久
国模国产精品嫩模大尺度视频
亚洲男人天堂2021
亚洲中文视频一区二区三区
国产成人精品2021欧美日韩
欧美日韩久久中文字幕
99热这里只有成人精品国产
成人免费看吃奶视频网站
91大神网址
国产成人精品在线1区
五月婷丁香
亚洲AV日韩AV一区二区三曲
欧美成人精品福利视频
色欲人妻综合AAAAAAAA网
玖玖资源站亚洲最大成人网站
自拍偷区亚洲综合激情
亚洲色无码
国产免费va
国产偷窥熟女高潮精品视频
亚洲精品中文字幕乱码二区
五月天乱伦小说
www.av小说
欧美黄色网
99精品人妻少妇一区
亚洲一起cao
中文 国产 无码免费
久久宗合
午夜福利无遮挡十八禁视频
99热精品毛片全部国产无缓冲
免费视频A级毛片免费视频
亚洲第一区精品日韩在线播放
午夜天堂av久久久噜噜噜
男女性午夜福利网站
天堂无码
亚洲乱码日产精品一二三
国产H片无码不卡在线视频
色色aVav
天堂在线最新版资源
久久综合无码中文字幕无码TS
色吧偷人人操美女人人操美女
国产精品午夜av福利
乱伦视频网
亚洲综合瑜伽裤美女av
国产成人一区二区三区在线观看
精品精品国产欧美在线小说区
女人体免费一区二区
国产综合久久99久久
99插插
a天堂一码二码专区
国产精品一区二区不卡
久久亚洲午夜牛牛影视
久久久久成人精品免费播放网站
青青草精品在线新免费
天美mv天美mv天美mv
手机在线观看h中文字幕
亚洲人成色99999在线观看
夜夜国自一区
亚洲熟妇在线视频观看
色噜噜久久综合伊人一本
999国内精品久久免费视频
99久re热视频这里只有精品6
人妻精品影视在线观看
李毅吧500期最新更新后进
国产性天天综合网
日韩视频一区二区
精品国产成人高清在线
在线观看1024精品国产
3d动漫精品啪啪一区
久久久黄色片
亚洲综合图区中文字幕
狠狠色噜噜狠狠狠狠97首创麻豆
免费 无码 国产在线观看不卡
全免费A级毛片免费看网站
在线看A片
色悠久久久久综合网香蕉
在线人成精品免费视频
操亚洲无码
国产91特黄特色A级毛片
美女18禁网站
国产成人精品日本亚洲77上位
无码专区人妻系列日韩精品少妇
青草视频在线观看入口
久久中文骚妇内射
亚洲中文无码天堂一区二区三区
99久久久国产精品免费无码专区
一级一级特黄女人精品毛片
中国产无码一区二区三区
中文天堂最新版资源www
日韩黄色免费电影
强伦姧人妻免费无码电影
国产精品亚洲在钱视频野战
朝鲜女人大白屁股ASS孕交
成人久久18免费网站入口
国模少妇无码一区二区三区
国内精品久久久久影院日本
日韩精品不卡一区二区三区
玩弄放荡人妻少妇在线
日韩a在线观看免费观看
中文字幕成人电影
精品国产福利一区二区在线
日韩小电影
国产精品AV在线
久久综合网络一区二区
亚洲中文在线一区二区
亚洲AV无码成人精品区蜜桃
成人国成人国产SUV
www中文字幕在线观看
久久aⅴ无码av高潮AV喷
秘色aⅴ一区二区三区
精品人妻无码专区中文字幕
中文字幕亚洲专区第19页
久久亚洲欧洲日产国码
精品香蕉在线观看视频
亚洲日韩精品无码专区网址
熟妇网
久久足交
亚洲欧美成人中文日韩电影网站
国产品精品久久久久中文
jizzjizz18国产
亚洲成AV人片在线观看WWW
毛片一区二区在线看
日本一区二区久久精品亚洲中文无
jizz国产
综合久久9
狠狠色噜噜噜噜狠狠狠狠狠狠奇米
国内揄拍国内精品少妇国语
国产午夜亚洲精品不卡网站
成人免费午夜福利片在线观看
国产99视频精品免费专区
久久久久无码精品国
中文一区二区
国产精品亚洲А∨天堂免下载
欧美洲精品亚洲精品中文字幕
亚洲AV日韩AV综合在线观看
欧美A视频
国产午夜手机精彩视频
在线观看麻豆
国产麻豆成人传媒免费观看
成本人无码h无码动漫在线网站
亚洲AV乱码久久精品蜜桃
久久偷拍视频只有精品
亚洲日本无码一区二区在线观看
中文乱码人妻系列一区
亚洲中文字幕毛片在线播放
久久国产亚洲精品赲碰热
亚洲AV永久无码精品水牛影视
免费av网站
美女裸体无遮挡免费视频网站
国产激情婷婷丁香五月天
国产色资源
美女视频黄a视频免费全过程
亚洲午夜久久久久久久久久
国产视频一区二区视频
尤物193在线人妻精品免费
狠狠丁香激情久久综合
日本久久免费精品观看
欧美日韩亚洲国内综合网香蕉
久久精品无码专区东京热
国产嫩草久久久一二三久久免费观看
久久久精品人妻一区二区三区四
传媒剧在线mv免费在线观看
亚洲人妻高清无码
无码人妻精品一区二区三区蜜臀百度
亚洲国产一区二区三区四区电影网
亚洲色播永久网址大全
久久福利影院
丝袜国产在线
两个人看的视频WWW在线高清
91精品国产一区自在线拍
国产精品福利一区二区久久
你懂的福利视频
久久久久久久成人午夜精品福利
亚洲AV香蕉一区区二区三区
国产成人精品无码一区二
精品伊人久久大香线蕉网站
欧美家庭乱伦XX
免费一级特黄毛片视频
国产精品爽爽va在线观看无码
日韩日韩日
久久综合国产色美利坚
国产福利导航在线
天堂mv在线mv免费mv香蕉
日本激情网站
欧美在线视频99
亚洲VA中文字幕无码毛片
狠狠色丁香婷婷综合久久来来去
人妻无码日韩精品中文
国产精品香蕉一区二区三区
国产精品久久中文字幕
亚洲国产欧美一区三区成人
岛国av在线播放观看
无码中文字
日韩高清在线亚洲专区观看
韩国一区二区免费
欧美精品?-?老A传媒有限公司
精品国产乱子伦一区二区三区,精品一
99成人精品
香蕉成人短视频app免费推广
国产嫩草视频一区二区
亚洲一本网
亚洲人妻中文字幕在线视频
www.天天操.com
视频一区二区三区蜜桃麻豆
亚洲国产麻豆一区二区三区
污网站免费看
成本人无码h无码动漫在线网站
a片无码高清免费视频播放
九九精品国产亚洲AV日韩
国产精品高潮呻吟av久久
欧美一区二区三公司
国产精品成人一区二区三区视频
免费av在线播放观看
人人妻人人添人人爽欧美一区
精品国产av无码一道
欧美极品色午夜在线视频
四虎无码精品a∨在线观看
成人做受黄大片
国产日韩欧美在线观看不卡
亚洲精品1区2区
久久96热在精品国产高清
精品国产自在现线电影
本道无码一区二区久久激情
97精品国产福利一区二区三区
国产精品亚洲综合久久
夜夜cao
国产又爽又黄无遮挡免费观看
91精品免费久久久久久久久
亚洲AV无码秘 蜜桃1区
在线永久免费观看黄网站
国产精品自拍视频入口
怡红院亚洲
亚洲色大成网站www久久九
国产亚洲欧美在线播放网站
亚洲激精日韩激情欧美激情精品
亚洲高清无码视频网站在线
亚洲日本韩在线观看
japan黑人极大黑炮
在线无码国产精品亚洲а∨
色播五月丁香
久久riav一区二区
日本无码一区二区
国产精品久久无码不卡黑寡妇
欧美亚洲国产丝袜在线
芒果视频天天看片天天爽
日韩在线一区二区
国产精品电影
白丝美女办公室高潮喷水视频
tom影院亚洲国产日本一区
97人妻在线
啪啪啪啪啪网站
狠狠色狠狠爱综合蜜芽五月
亚洲国产成人资源在线
亚洲女同精品中文字幕
久久日韩在线观看视频
国产亚洲精品va在线
www日韩
无码网
日韩人妻无码一区二区三区综合
成人国产在线永久免费
久久亚洲精品成人AV无码网址
亚洲国产精品yw在线观看
国产精品区免费视频
亚洲日韩AV一区二区三区中文
亚洲免费无码三级片
少妇福利导航
国产福利片无码区在线观看
老子影院午夜精品无码
亚洲成a人片在线不卡一二三区
中日韩三级片
国产日韩操人
欧美特黄一级大黄录像
另类综合30p
√最新版天堂资源在线
18禁成人免费无码网站
国产精品久久久久孕妇
久久综合久久自在自线精品自
国产AV影院
日韩在线视精品在亚洲
少妇xxxxx性开放
9传媒剧在线mv在线看
久久久婷婷亚洲5月97色
免费**毛片在线播放
丝袜美腿亚洲综合二区
亚洲欧美日韩中文综合在线不卡
国产久热免费观看视频
国产AV在
国产成人免费无码AV在线播放
国产69精品久久久久99尤物
欧美538顶级
成人三级毛片
最新国产麻豆aⅴ精品无
又硬又粗又长又爽免费看
国产亚洲日本人在线观看
日韩免费视频一一二区
9久9久女女热精品视频免费观看
国产初高中生视频在线观看
亚洲老女人区一区二视频
色偷偷亚洲男人的天堂
亚洲AV无码专区首页第一页
国产欧美日韩精品第二区
我被公睡做舒服爽中文字幕
狠狠躁夜夜躁人人爽超碰97香蕉
免费AV片在线观看无需播放器
性色一区二区三区av
久久AV无码精品人妻系列
深夜视频国产在线观看
久久99精国产一区二区三区四区
国产亚洲精品A在线无码
亚洲国产精品色一区二区
国产精品18
最新国产麻豆AⅤ精品无码
久操影视
国产在线精品乱码一区
最新久久激情综合
成人亚洲黄色av网站
久久夜色撩人精品国产小说
国产二区精品久久
国产精品美女
久久天堂av综合合色
国产乱人妻精品入口
国产国语一级毛片中文
国产jizzjizz全部免费观看
欧美玉足足交
日本少妇自慰免费完整版
国产精品免费看久久久香蕉
一区二区三区在线观看视频
98精品国产综合久久
成人av中文字幕在线播放
男人天堂av成人在线
在线三级精品视频
爽到高潮漏水大喷视频软件
狠狠色噜噜狠狠狠狠色综合久
国产亚洲视频免费播放
国产精品久久久天天影视香蕉
欧美97欧美综合色伦图
国产精品自拍啪啪视频
999re6在热线视频
欧美日韩国产在线人成app
亚洲综合社区
亚洲最大国产精品黄色
国产色视频网免费
第一宅男AV导航
亚洲精品国产情侣AV在线
久久人人爽av亚洲精品
美日韩一区二区综合在线视频
亚洲av伊人久久青青草原
久久中文字幕网站篠田优
精品熟女视频专区
成人rt网
AV永久天堂一区二区三区香港
欧美视频九九一区二区
国产妇女乱一性一交
欧美日韩精品一区二区
国内久久AV片
国产成人精彩在线视频
久久88香港三级台湾三级播放
亚洲AV日韩AV永久无码网站
久久99精品久久久久久9蜜桃
亚洲熟女国产熟女二区三区
久久精品国产91久久性色tv
欧美又粗又大
无码人妻一区二区
亚洲色频
brazzers精品成人一区
精品久久中文字幕五十路人妻
99热精品国产三级在线
亚洲一二三区精品美妇
A片在线不卡观看免费观看
国内成人综合
中文字幕亚洲乱码熟女一区二区
亚洲V天堂V手机在线
久久精品成人无码观看
一本色道久久综合亚洲精品高清
国产一区在线播放av
韩国av无码
亚洲无码日本
樱花草视频www日本韩国
欧美久久久久久
亚洲成人av在线系列
超碰97人人天天蜜芽
av免费网站
九九天堂
国模在线视频一区二区三区
亚洲国产日韩精品久久
一个色综合国产色综合
日日摸日日碰人妻无码
国产最近最新中文天堂
天堂男人2021av
国内自拍偷拍亚洲天堂
天堂在线观看av一区二区三区
男人天堂一区
久久精品国产99久久6动
av天堂亚洲
国产成人精彩在线视频
丰满少妇人妻无码超清
青青国产线免观
99热精品69堂国产
婷婷五月天社区
福利一区福利二区看片
日韩丝袜美腿在线观看
国产精品18久久久久久欧美
男人天堂av免费观看
午夜亚洲AV成人无码国产
欧美 偷窥 清纯 综合图区
亚洲中文视频一区二区三区
亚洲一区二区av
福利视频网址
久久色窝窝
欧美性猛交xxxx乱大交丰满
久热香蕉精品视频在线播放
色老头老太XXXXBBBB
丁香五月亚洲综合深深爱
www.黄
国产精品无码av在线播放
久久久久久性高
曰本女人牲交视频免费
97超碰精品成人国产
性感人妻中文字幕在线
日韩一区二区三区无码人妻视频
成人偷拍自拍在线观看
国产午夜成人无码免费看不卡
强开小婷嫩苞又嫩又紧视频韩国
国产精品一级av一区二区
国产人成亚洲第一网站在线播放
国产爆乳无码一区二区麻豆
国产精品久久久久久久影视一免费
国产妇乱子伦视频免费
产精品无码一区二区三区免费
国产jizzjizz视频
一本色道久久88亚洲综合
韩国精品视频一区二区在线播放
专区亚洲欧洲日产国码AV
国产嫩草精品网亚洲av
国产又爽又黄无遮挡免费观看
国产精品av中文字幕
国产精品手机在线亚洲
色妺妺在线视频喷水
午夜福利十八周岁成人
亚洲日韩午夜av不卡在线观看
中文字幕在线观看亚洲
久久一本色系列综合色
九九re6热在线视频精品66
91wwwww
欧美成人三级
精品国产一区二区色老头
国产精品 亚洲一区二区三区
四虎影视成人永久免费观看视频
久久狼人国产综合精品
国产二区精品久久
大乳丰满人妻中文字幕日本电影
欧美日批
国产精品久线在线播放
日韩av一区二区三区
午夜福利视频导航
麻豆av传媒蜜桃天美传媒
亚洲国产精品日韩专区
亚洲不卡
精品国产乱码久久久久久口爆
亚洲色大成网站WWW久久九九
国产免码VA在线观看免费
免费人成视频在线观看视频
jizz日本版
韩国一区二区三区
97午夜影院
国内精品视频区在线2021
五月综合激情久久婷婷
亚洲成年人福利专区
精品福利一区二区三区
91丨牛牛丨国产人妻
加勒比亚洲视频在线播放
久久久久久九九99精品
日日射天天操
欧洲少妇性喷潮
国语做受对白xxxxx在线
免费H片
東北老熟女黃色A片
欧美日韩高清在线
午夜亚洲AV成人无码国产
国产精品三级国产专不
69精品人人人
久爱精品视频在线视频
狠狠色噜噜狠狠狠97影音先锋
亚洲狠狠网站色噜噜
亚洲第一区精品日韩在线播放
亚洲色9
亚洲成人不卡
亚洲天天干
狠狠狠狠狠
夜福利导航
69堂在线观看线无码视频一
中文字幕久久久久人妻
不卡无码AV一区二区三区
欧美日韩精品一区二区视频
尤物一区
在线亚洲午夜理论AV大片
成人福利社
四虎在线中文字幕一区
2022年国产精品久久久久
91无码丝袜
91久久偷偷做嫩草影院电
国产美女视频免费观看的网站
日本午夜视频
精品亚洲国产成人蜜臀AV
JIZZJIZZJIZZ亚洲日本
国产精品被熟女
又黄又湿又爽的视频
级毛片久久久毛片精品毛片
777亚洲精品乱码久久久久久
精品国产高清自在线一区二区三区
亚洲欧美另类小说
亚洲乱码精品一区二区
狼友看片
欧美精品亚洲精品日韩传电影
国产片AV国语在线观看手机版
中文字幕国产精品资源
久久亚洲国产中v天仙www
中文字幕一区二区在线观看
九九热精品免费视频
亚洲高清在不卡一区二区三区
亚洲综合极品嫩模喷大量白浆
久久人人久久人人
国产Av无码精品色午夜
精品国内在视频线最新
日本不卡二区高清三区
97狠狠狠狼鲁亚洲综合网
国产黄色污一区二区三区
白嫩少妇丰满一区二区
亚洲一区二区三区av链接
人妻丰满熟妇av无码片
尤物视频在线
在线精品亚洲一区二区小说
国产中文三级全黄
国内精品久久九九国产精品
欧美肥老太牲交大战
国产添下面视频全过程教程
日韩人妻无码一区二区三区综合部
色人妻中文字幕
色午夜久久男人操女人
亚洲国产迷
久久国产精品娇妻素人
精品国产成人高清在线
又大又长粗又爽又黄少妇毛片
国产嫩草视频一区二区
五月综合激情婷婷六月色窝
亚洲欧美另类中文字幕
777色婷婷
欧美一区二区精品系列在线观看
日本高清视频www夜色资源
亚洲av观看
中国国产一级毛片视频
极品人妻一区
精品国产电影久久九九
人妻制服丝袜中文字幕
人妻老妇乱子伦精品无码专区
国产乱理伦片在线观看
91人妻熟妇在线视频
日本欧美视频在线观看三区
国产一区二区丝袜美腿
www.啪啪白浆
国产一级做a爱视频在线
色爱无码综合网
亚洲综合久久综合激情久久
日韩av无码精品人妻系列
东京热久久综合久久88
国产精品视频二区不卡鸭子tv
久久久久久无码人妻中文字幕
七七AV
99在线观看视频只有精品
在线亚洲AV成人无码
中文字幕成人
日韩免费无码视频一区二区三区
九九在线精品
色偷偷亚洲精品一区二区
色老头久久综合网老妇女
人妻免费一区二区三区最新
免费看又黄又爽又猛的视频软件
久久精品国产亚洲AⅤ无码剧情
亚洲色9在线
国产拍揄自揄精品视频网站
一级欧美牲交大片免费观看
99热成人精品国产免
亚洲欧洲激情
免费看国产成年无码av
www.欧美乱伦.con
国产成人综合亚洲网址
中文乱码人妻系列一区
久久精品国产免费观看频道
久久狠狠中文字幕2017
亚洲熟妇色XXXXX欧美老妇Y
99在线精品免费视频九九视
国产美女精品一区二区
日本久久激情
人妻精品中文久久一区
久久精品丝袜高跟鞋
综合88av
男女肉粗暴进来120秒
国产精品一二三
欧美日韩一
中文字幕第8页
国产国产+人+综
国产va欧美va在线观看
精品国际久久久久999波多野
国产成人午夜91精品麻豆剧场
中文字幕日产乱码中
caoporn成人免费公开
最新精品露脸国产在线
成人一区二区国产精品
五月丁香综合
青青草福利导航
精品黑人一区二区三区国语馆
欧美性高清极品猛交
久久99精品久久久久久9
国产午夜在线观看
中文字幕久久国产精品
亚洲国产综合91麻豆
自拍偷自拍亚洲精品被多人伦好爽
日韩成人综合
国产成人精品久久二区二区
99久久99久久免费精品小说
久久99久久成人免费播放
蜜臀AⅤ永久无码一区二区
91福利姬
国产精品99久久久精品免费观看
亚洲日本国产一区二区精品成人
萌白酱国产一区二区
久久综合结合久久很很很97色
亚洲av乱码一区二区三区女同
大陆精大陆国产国语精品1024
日韩成人小电影
美女视频黄的全免费视频网站
亚洲欧美不卡中文字幕
免费无码av
成人三级小说
久久亚洲AV无码精品色午夜麻
国产av剧情md精品麻豆
伊在人香蕉99久久
亚洲天堂av在线一区
午夜成人免费视频
H色无码网站
一区二区在线视频大片
超碰老熟妇AV
人人妻人人做人人爽夜欢视频
丰满无码人妻热妇无码区
无码人妻丝袜在线视频
日韩人妻无码中文字幕视频
日日橹狠狠爱欧美超碰
狂野欧美激情性XXXX在线观看
亚洲一区精品自拍视频
亚洲午夜精品国产电影在线观看
亚洲男人AV香蕉爽爽爽爽
国产又爽又黄无遮挡免费观看
无码中文AⅤ在线观看
亚洲久悠悠色悠在线播放
影音先锋人妻啪啪AV资源网站
99久久精品久久久久久婷婷
日韩精品av免费在线观看
午夜无码区在线观看
日韩一三区
国产亚洲自拍av在线
福利姬无遮挡H福利网站
亚洲免费a级av
一个人www
日屄在线观看
亚洲国产AV玩弄放荡人妇
国内欧美亚洲综合视频
WWW夜片内射视频在观看视频
亚洲人妻视频
中文字幕日本最新乱码视频
国产午夜精品久久久久免费视
一道久久爱综合久久爱
久久人与动人物A级毛片
亚洲情综合五月天婷婷丁香
国产高清在线精品一区二区三区
欧美一级片在线观看
国产激情久久久久影院老熟女
性刺激的大陆三级视频
日韩免费一区二区三区在线
自拍一区在线视频观看
免费精品国产自产拍在线观看
亚洲一区二区三区在线观看精品中文
国产精品不卡一二三区
91制服丝袜国产高清在线
99久久er热在这里只有精品99
一区二区三区福利午夜
国产福利导航在线
2021久久精品永久免费
国产精品成人观看视频国产
黄色段片一区二区三区
18禁又污又黄又爽的网站不卡
日韩人人天天
97se亚洲综合在线天天
亚洲AV成人无码网站一区二区
亚洲色图天堂
亚洲人成网线在线播放va
国产理论最新国产精品视频
日韩第1页
日韩av中文字幕有码
午夜精品久久久久9999
国产在线观看播放av
国产午夜福利精品一区二区三区
美女一级毛片免费观看97
国产高清在线a视频大全
99热这里只有精品2
亚洲国产成人无码网站
国产超碰人人做人人爽AV
不卡动漫av
久久精品午夜一区二区福利
中文精品人妻
久久福利影院
99精品热视频
亚洲欧美不卡中文字幕
精品无码人妻av受辱日韩
日本高清一区二区不卡视频
一本一道AⅤ无码中文字幕
制服丝袜亚洲无码
久久人人玩人妻潮喷内射人人
无码熟妇人妻AV在线影片最多
久久久久成人精品
无码AV在线播放
人妻中文字幕精品系列
中文字幕在线视频不卡
亚洲色avav
婷婷五月综合缴情在线视频
在线无码视频观看草草视频
99久久精品免费视频
国产精品久久久久久久久久久久
亚洲av黄片一区二区
国产成人精品曰本亚洲
麻豆精东
亚洲AV无码专区国产乱码DVD
99re视频这里只有精品
久久久久久久综合综合狠狠
亚洲AV激情无码专区在线下载
av在线观看在线播放
综合激情中文字幕一区二区
成人免费无遮挡在线播放
98久免费精品视频在线观看
成人深夜节目在线观看
精品熟人妻一区二区三区四区不卡
狼人视频国产在线视频www色
国产羞涩免费视频在线观看
免费又爽又刺激高潮网址
亚洲中字幕
日日碰狠狠添天天爽五月婷
亚洲中文字幕播放
国产小视频在线高清播放
一区二区激情
日本亚洲综合伊人久久
波多野吉衣亚洲Av无码
国产Av专区
亚洲丰满熟女一区二区V
亚洲精品v欧美精品动漫精品
久久深夜福利
久久精品国产999大香线焦
亚洲欧洲日韩久久狠狠爱
久久天天躁狠狠躁夜夜婷
国产亚洲精品xxx
国产69精品久久久久99
日韩欧美精品
国产一级三级视频在线
国产精品综合久久久久久久免费
一本色道久久综合狠狠躁
91久久精品国产免费一区
四季亚洲AV永久无码精品尤物app
在线播放免费av大片
96国产精品自拍视频
人成视频在线观看
日本a级精品一区二区三区
成 人 黄 色 免费 网站
日韩午夜激情
99在线国内在线视频22
在线播放亚洲成人av
久久国产乱子伦视频无卡顿
亚洲成人国产一区二区
日日摸日日添日日躁
免费**毛片在线播放
亚洲精品尤物av在线网站
依依成人影视国产精品
久操视频在线免费观看
国产精品久久久久久福利
精品夜恋影院亚洲欧洲
亚洲欧美精品成人久久91
超碰人人草
国产综合在线视频_亚洲日韩在线观
欧美又粗又长又爽做受
午夜亚洲国产理论片4080
久久精品国产亚洲AV成人毛片
中文字幕av无码专区第一页
精工厂无码视频
国产私拍大尺度在线视频
欧美国产菊爆免费观看
超碰aⅴ人人做人人爽欧美
亚洲成AV人国产毛片
a毛片在线看片免费看
天天肏屄
西西人体444www高清大胆
在线精品亚洲一区二区绿巨人
亚洲AV无码一区二区三区在线观看
亚洲欧美日韩在线资源观看
久草一牛va
精品国产中文一级毛片在线看
人人澡人人模人人爽手机版
67pao国产成视频永久免费
亚洲人成网站www
成人污视频在线观看
国产在线尤物在线不卡网站
jizzjizzjizzjizz
福利社试看一分钟
AV毛片无码中文字幕不卡
中文字幕亚洲综久久2021
亚洲AV无码一区二区三区在线
日本中文字幕有码在线视频
亚洲综合色婷婷在线观看
国产爆乳乱码女大生Av
少妇被粗大的猛烈进出96影院
久久一本日韩精品中文字幕屁孩
国产黑色丝袜在线观看片不卡顿
人妻无码久久一区二区三区免费
黄色三级片视频
色 综合 欧美 亚洲 国产
99成人精品
玩两个丰满老熟女久久网
无码AⅤ天堂一区二区三区
久久99精品国产麻豆婷婷
国产一区二区人大臿蕉香蕉
亚洲成a人片777777
欧美深到肚子的全臂交
中文字幕一区二区在线网站
国产性自爱拍偷在在线播放
人妻少妇被猛烈进入中文字幕
中国一区二区视频
日韩欧美精品
k频道国产在线观看
曰本三级香港三级人妇99视频
9191精品国产免费久久国语
日韩中文网
欧美乱妇狂野欧美在线视频
国产黑丝视频在线观看
成年女人免费视频播放体验区
日韩综合另类
亚洲无码精选
国产精品综合色区在线观看
,国产乱人伦无无码视频
国产精品资源管理站在线直播
国产一区二区在线观看视频
国产精品人妻一区二区三区
夜精品a一区二区三区
亚洲一区精品自拍视频
日韩人妻无码精品久久
在线观看一区二区驻马店
欧美日韩亚洲综合二区
永久免费看mv网站入口亚洲
综合一区二区
日韩专区中文字幕
囯产精品无码va一区二区
国产新疆成人a一片在线观看
大香蕉一区
最新福利姬在线视频国产观看
亚洲国产精品高清在线电影
国产精品自拍啪啪视频
欧美视频一区二区三区
91福利国产在线在线播放
精品偷拍视频在线观看
亚洲av日韩av无码尤物
av天堂永久资源网亚洲高清
狠狠色狠狠综合久久
久久精品免费视频久久
亚洲人成毛片线播放
欧美黑人粗暴多交高潮水最多
一级做a爰片久久毛片下载
一区二区不卡国产精品
国产精品R级最新在线观看
欧美亚洲国产精品久久
肥女五十路
久久国产精品成人免费古装
亚洲中文字幕无码不卡电影
欧美 日韩 人妻 高清 中文
日韩视屏二区
成人国产精品中文字幕
18禁超污无遮挡无码免费游戏
色哟哟中文字幕在线
一区二区久久
伊人激情综合中文字幕
试看小视频
蜜桃视频一区在线观看
成视频年人黄网站免费动漫
少妇爆乳无码av无码波霸
40分钟永久免费又黄又粗
亚洲精品精华液一区
aa中文化产品产二区在线
成人片黄网站色大片免费观看CN
亚洲午夜伦费影视在线观看
第一页在线
高潮少妇高潮少妇av
99久久综合狠狠综合久久男同
日韩在线看片中文字幕不卡
亚洲中文无码手机永久
国产公开久久人人97超碰
国产精品亚洲专区一区二区
亚洲中文字幕人妻诱惑
亚洲人成网站观看在线观看
99热成人精品热久久66
成人性爱免费视频
亚洲国产日韩精品久久
91中文字幕一区在线
亚洲首页精品国产首页
亚洲综合成人av在线
丰满熟女人妻中文字幕免费
国产草莓精品国产AV片国产
福利姬导航
116美女极品a级毛片
波多野结衣制服丝袜中文字幕
免费观看无码视频
91热久久免费频精品99欧美
亚洲精品国产成人AV蜜臀
日日插中文字幕
在线视频一区二区三区
夜色资源站国产www在线视频
日本乱码伦在线观看
日韩精品亚洲专区在线观看
91蝌蚪视频在线观看
人妻精品无码1区
久久综合九色综合色
a片一区二区三区
伊人88
国产男女猛烈无遮挡免费视频网站
亚洲精品一区国产精品
国产精品国产AV片国产
xxxx丰满少妇高潮
东京热av无码电影一区二区
成在线人免费无码高潮喷水
婷婷97狠狠做五月深爱婷婷
精品国产Av电影无码久久久
亚洲人妻精品视频
亚洲国产一区二区视频
国产亚洲精品视频中文字幕
狠狠色综合欧美激情
69堂在线观看线无码视频一
亚洲第一页中文字幕
成人国成人国产SUV
亚洲成av人片在线播放
亚洲AV无码精品色午夜在线观看
小鲜肉洗澡时自慰网站XNXX
成人毛片一区二区
精品人妻中文av一区二区三区
久操香蕉
中文字幕日韩一区二区不卡
中文字幕精品一区二区三区精品
97热这里只有精品
无码国产精品免费看
欧美激情乱伦
人人妻人人添人人爽欧美一区
国产性一交一乱一伦一色一情
无码人妻aⅴ一区二区三区蜜桃
一本大道在线一久道一区二区
国产精品被窝福利一区
亚洲国产综合AV
亚洲av熟女天堂系列
最大色网男人的av天堂
亚洲h网一区二区三区
四虎国产精品永久在线动漫
日韩城人网
精品久久国产老人久久综合
性交小视频
岛国av在线免费播放
无码精品黑人
老熟妇一区二区三区啪啪
高潮一区二区三区av
天天色日韩
国产老熟女伦老熟妇露脸
午夜福利2025
日本免费一区二区三区中文
日韩在线不
精品无码黑人又粗又大又长
国产亚洲AV三级
一区二区三区AV波多野结衣
亚洲日韩操
又湿又紧又大又爽又A视频
69sex久久精品国产麻豆
狠狠色噜噜狠狠米奇777
在线www
3P免费视频在线观看
无码性午夜视频在线观看
国产精品xxx
精品免费视频
狠狠五月天中文字幕
亚洲一码二码在线观看

.png)


.png)
.jpg)
.jpg)


